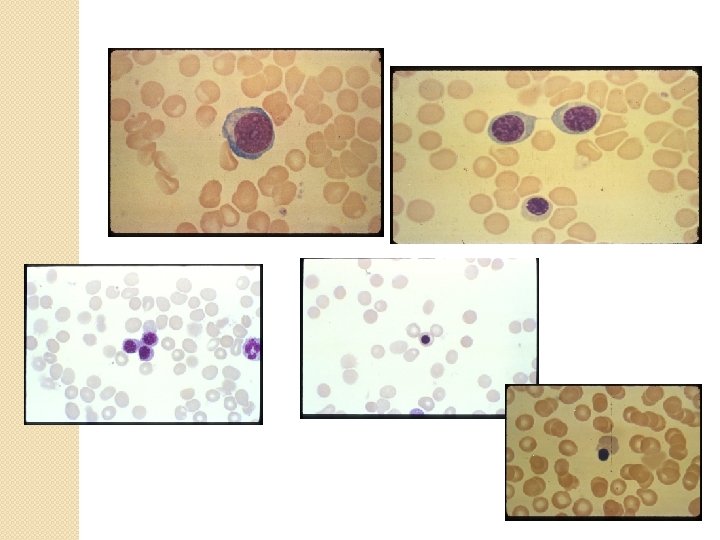

Hematopoeisis Bone marrow Erythropoiesis RBC structure and function

Hematopoeisis, Bone marrow, Erythropoiesis, RBC structure and function Faisal Klufah M. S. H. S, MLS(ASCP)

Objectives § § § § Define hematopoiesis Describe the origin of hematopoieisis Define erythropoiesis List proper cell maturation of the erythrocytic series Identify three areas of RBC metabolism crucial for normal erythrocyte survival and function Describe RBC membrane biochemical structure and the consequences of structural membrane defects RBC metabolic pathways

Hematopoeisis

Tissue homeostasis ◦ Maintenance of an adequate number of cells through these functions: ◦ Proliferation ◦ Differentiation ◦ Death (apoptosis)

Cell cycle �G 1 S G 2 M �S phase - DNA synthesis �M phase – mitosis

Apoptosis vs Necrosis �Necrosis: cell death by lethal chemical, biological or physical events �Apoptosis : programmed cell death regulated by genetic material of cell

Hematopoiesis Blood cell formation – production and development § Occurs bone marrow, liver, spleen, lymph nodes, thymus § Bone marrow – sole site of effective hematopoiesis in normal adults § § 6 billion cells/kg of body weight per day § 2. 5 billion red cells § 2. 5 billion platelets § 1. 0 billion white cells Rate adjusted to need, vary from nearly zero to many times the normal § Constant turnover of cells §

Definition of HEMATOPOIESIS �Development of different cell lineages in blood �Differentiation ◦ Appearance of different properties in cells �Commitment ◦ Cells derived from common precursors take separate routes ◦ Maturation occurs from commitment to fully developed cell

Ontogeny of Hematopoeisis �Yolk sac > fetal liver/spleen > �Three developmental periods ◦ Mesoblastic ◦ Hepatic ◦ Myeloid BM

Mesoblastic �Blood islands of yolk sac �Primarily RBC production �Embryonic hemoglobin produced

Hepatic �At 6 weeks cell production in liver �Fetal hemoglobin produced �Spleen, thymus, lymph nodes also active production

Myeloid �At 5 th month Bone Marrow becomes site of cell production �Liver & spleen now Extramedullary �Hemoglobin A ( 2 2)

Hematopoietic precursor cells �Stem cells �Progenitor cells �Maturing cells


Stem Cells § Very small group of cells § Multipotential cells that give rise to all lineages of blood cells § High self-renewal ability § Not morphologically distinguishable § Identified by flow cytometry with marker CD 34 § Supporting research


Progenitor Cells �Committed cells to differentiation into cell lines �Described as colony-forming units (CFU) ◦ CFU-GEMM ◦ CFU-GM ◦ CFU-Meg �Population amplified by proliferation

Maturing cells �Majority of precursor cells �Recognizable morphologic characteristics �Nomenclature unique for each cell line

Cytokines & Growth Factors § Cytokines § Govern precursor cell survival, self-renewal, proliferation, differentiation § Growth factor control § Interleukins numbered according to discovery Growth factors promote cell survival by suppressing apoptosis § Growth factors promote proliferation §

Lineage specific cytokines �Erythropoiesis ◦ BFU-E ◦ CFU-E dependent on EPO �Granulopoiesis and Monopoiesis ◦ CFU-GM supported by IL-3 �Megakaryocytopoiesis ◦ CFU-Meg induced by IL-11 and TPO �Lymphopoiesis ◦ Multiple GF in development of T & B cells

Bone Marrow

Bone marrow �Bone ◦ marrow/ medullary hematopoiesis Major hematopoietic organ �Blood forming tissue located between trabeculae ◦ Bone marrow stroma is supporting tissue for hematopoietic cells ◦ Red marrow/yellow marrow

Thymus �Lymphopoietic organ in upper mediastinum �Cortex densely packed with small lymphocytes � Primary purpose ◦ Compartment for maturation of T lymphocytes ◦ Precursor T cells leave the bone marrow and enter the thymus

Spleen �Upper left quadrant of abdomen �Richly supplied with blood � Functions include ◦ culling; filtering and destruction of old or damaged RBCs ◦ Pitting: pluck our particles from RBCs ◦ immune defense ◦ storage: hold 1/3 of platelets

Lymphatic system �Lymph nodes and lymphatic vessels �Nodes remove foreign particles from lymph �Functions ◦ Immune defense ◦ B cell production in germinal centers

Erythropoiesis

Erythron �Total population of erythrocytes and precursors in peripheral blood and bone marrow ◦ RBC production ◦ RBC release ◦ RBC destruction �Primary signal regulating RBC production is oxygen tension ◦ tissue oxygenation due to anemia or pulmonary insufficiency

Erythropoiesis �Stimulated by Erythropoietin (EPO), a glycoprotein hormone produced in the kidney �EPO accelerates commitment of pluripotent stem cell to CFU-E and erythroid development

Maturation characteristics �Cells accumulate hemoglobin �Lose their protein-synthesizing apparatus �Nuclear chromatin pattern changes �cells become smaller �Nucleus to cytoplasm ratio decreases

Sequence of RBCs Maturation �Pronormoblast �Basophilic normoblast �Polychromatic normoblast �Orthochromic normoblast �Reticulocyte �Erythrocyte

All stages of erythropoeisis http: //www. tau. ac. il/~inter 05/eryt. htm

RBC structure and function

RBC Membrane Composition �Trilaminar structure ◦ outer hydrophilic ◦ central hydrophobic ◦ inner hydrophilic �Proteins ◦ integral: Extend from outer surface to inner ◦ peripheral: cytoplasmic surface beneath lipid bilayer

Schematic of RBC membrane

RBC Membrane Lipids � 95% of lipid content ◦ Unesterified Cholesterol ◦ Phospholipid bilayer �Remaining 5% ◦ Glycolipids � Antigenic properties of the membrane ◦ Free fatty acids

Membrane Proteins: Integral �Integral ◦ Glycophorin A, B, C � Carry RBC antigens and give the RBC it’s negative charge ◦ Band 3 � Functions as anion exchange protein

Membrane Proteins: Peripheral �Peripheral (form membrane “skeleton”) ◦ Contribute to cell shape, membrane stability, deformability and gives it the viscoelastic properties

RBC Deformability ◦ Flexibility of the RBC to squeeze through capillaries ◦ Increased conc of hgb or decreased fluidity = decreased deformability. ◦ Accumulation of membrane calcium result in rigid, shrunken cells & reduced deformability

RBC Permeability ◦ Freely permeable to H 2 O, Cl-, ◦ Cation pump regulates balance of Na+and K+

RBC Metabolism �Limited because of absence of nucleus, mitochondria, and other organelles �Pathways described contribute energy to maintain : ◦ high intracellular K+, low intracellular Na+, very low intracellular Ca++ ◦ Hemoglobin in reduced form ◦ Membrane integrity and deformability

Pathways: 1 - Embden-Meyerhof Pathway 2 - Hexose Monophosphate Shunt 3 -Methemoglobin reductase 4 -Rapoport- Luebering Shunt

Pathways: Embden-Meyerhof Pathway � 90 -95% of rbc glucose consumption �Glucose enters cell by diffusion and metabolized to lactate �net gain of two moles of ATP/mole of glucose �Key enzymes: pyruvate kinase, phosphofructokinase �Key role: ATP necessary for RBC shape, flexibility and membrane integrity

Gylcolysis in RBCs http: //www. vet. ed. ac. uk/clive/cal/RUMENCAL/Info/inf. Ferm. html

Hexose Monophosphate Shunt �produces reduced NADPH and reduced glutathione(GSH) �Functionally dependent on G 6 PD �GSH protects cell from permanent oxidant damage �Key enzymes: glutathione reductase, G 6 PD �Key role: maintain reduced GSH and reduced NADP

Diagram of HMS http: //www. uq. edu. au/vdu/Hexose. Monophosphate. Shunt. gif

Methemoglobin reductase �Pathway that maintains heme iron in reduced ferrous (Fe 2+) �Hgb in ferric state is methemoglobin(Fe 3+) �Key enzyme: methemoglobin reductase �Key role: prevent hypoxia

Rapoport- Luebering Shunt �causes accumulation of 2, 3 DPG thus regulating oxygen delivery to the tissues. �Key enzyme: DPG-synthetase �Key role: affects oxygen affinity of hemoglobin

Erythrocyte Destruction � RBC begins to undergo senescence � Reticuloendothelial System (RES) daily removes 1% of old RBCs via macrophages � As RBC ages, glycolytic enzymes decrease activity resulting in less energy and less deformability

Extravascular Hemolysis �Occurs in RES macrophages ◦ 90% of RBC destruction ◦ iron returned to erythroid precursors ◦ globin amino acids returned to AA pool ◦ heme protoporphyrin ring disassembled. ◦ Balances RBC number with production and use

Intravascular Hemolysis ◦ 5 -10% rbc destruction(within blood vessel) ◦ Free hemoglobin in the blood ◦ Iron bound to transferrin ◦ Released Hgb complexed to haptoglobin therefore decreased haptoglobin in the plasma

- Slides: 57